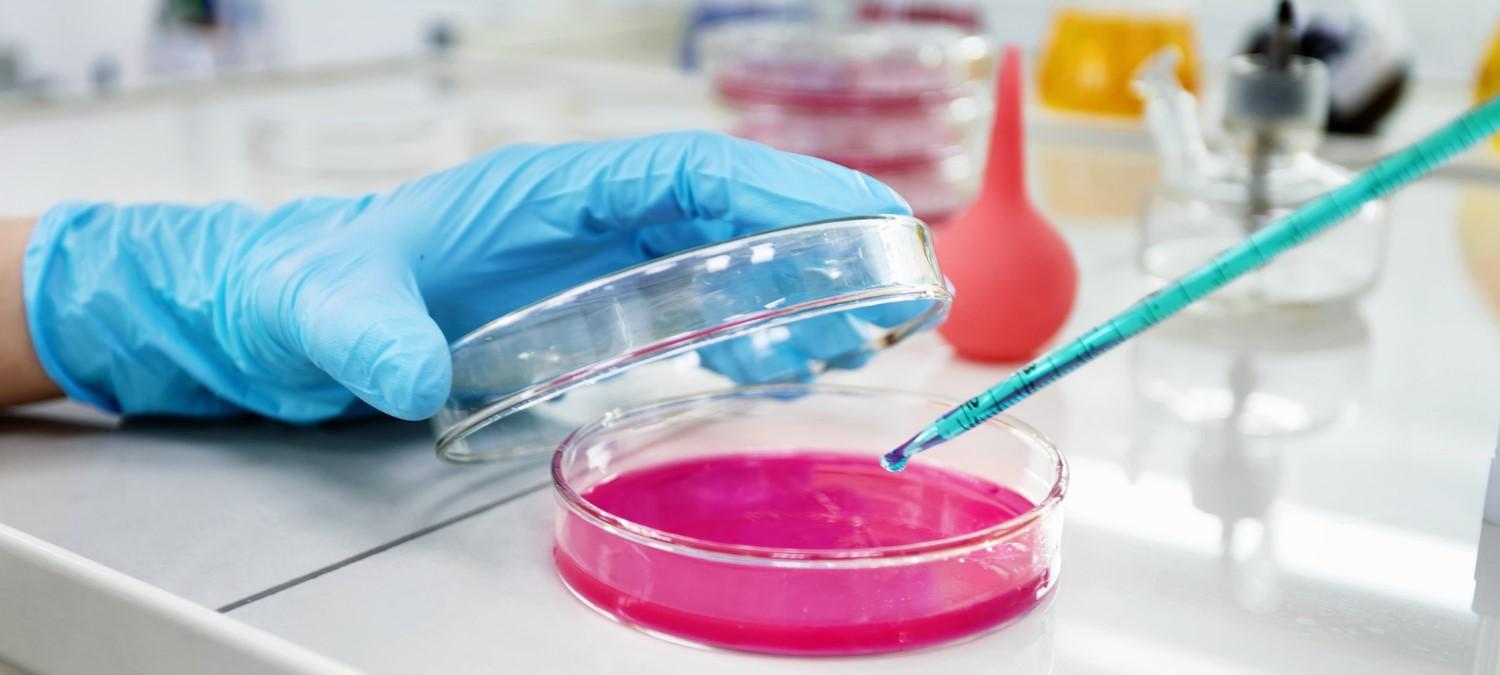

Cancer is one of the leading causes of death worldwide, with millions of new cases diagnosed each year. Traditional methods of cancer diagnosis involve invasive procedures like biopsies, which can be painful and carry risks of complications. However, there is now a new type of diagnostic test called liquid biopsy that offers a non-invasive and more convenient way of detecting cancer. In this blog, we'll take a closer look at liquid biopsy and how it works.
What is Liquid Biopsy?
A liquid biopsy is a diagnostic test that involves analyzing a patient's bodily fluids for signs of cancer. The most common type of liquid biopsy is a blood test, which involves extracting a small amount of blood from the patient and analyzing it for cancer cells or cancer-specific biomarkers. Other types of liquid biopsy can involve analyzing other bodily fluids such as urine, saliva, or cerebrospinal fluid.
Liquid biopsy is a relatively new technology, and it has the potential to revolutionize cancer diagnosis and treatment. Unlike traditional biopsies, which involve removing tissue from the body, liquid biopsy is non-invasive, and it can be done more frequently to monitor cancer progression and treatment effectiveness.
How does Liquid Biopsy Work?
Liquid biopsy works by detecting the presence of cancer cells or cancer-specific biomarkers in the patient's bodily fluids. These cancer cells or biomarkers can be shed by the tumor into the bloodstream or other bodily fluids, allowing them to be detected through a blood test or other liquid biopsy.
There are two main types of biomarkers that can be detected through liquid biopsy: circulating tumor cells (CTCs) and cell-free nucleic acids (cfNAs). CTCs are cancer cells that have broken away from the primary tumor and entered the bloodstream. These cells can be detected through a blood test and analyzed for cancer-specific genetic mutations or other biomarkers.
CfNAs are small fragments of DNA or RNA that are released into the bloodstream when cells in the body die. When cancer cells die, they release cfNAs that contain cancer-specific mutations or other biomarkers. These fragments can be extracted from a blood sample and analyzed to detect the presence of cancer.
Applications of Liquid Biopsy
Liquid biopsy has many potential applications in cancer diagnosis and treatment. Here are a few examples:
Early cancer detection: Liquid biopsy can be used to detect cancer at an early stage when it's more treatable. By analyzing a patient's blood for cancer cells or biomarkers, doctors can detect cancer before it has had a chance to spread to other parts of the body.
Monitoring cancer progression: Liquid biopsy can be used to monitor the progression of cancer and track the effectiveness of treatment. By analyzing a patient's blood for changes in CTCs or cfNAs, doctors can determine whether the cancer is responding to treatment or if it's spreading to other parts of the body.
Identifying targetable mutations: Liquid biopsy can be used to identify cancer-specific genetic mutations that can be targeted with specific treatments. By analyzing a patient's blood for specific mutations, doctors can tailor treatment to the patient's specific type of cancer.
Advantages and Limitations of Liquid Biopsy
Advantages:
Non-invasive: Liquid biopsy is a non-invasive diagnostic test that doesn't require tissue to be removed from the body, which can be painful and carry risks of complications.
Convenient: Liquid biopsy can be done more frequently than traditional biopsies, allowing doctors to monitor cancer progression and treatment effectiveness more closely.
Early detection: Liquid biopsy can detect cancer at an earlier stage when it's more treatable.
Tailored treatment: Liquid biopsy can identify cancer-specific genetic mutations that can be targeted with specific treatments, allowing for more personalized and effective treatment.
Liquid Biopsy Market Overview
The Liquid Biopsy Market has been growing rapidly in recent years, driven by the increasing prevalence of cancer and the need for more accurate and non-invasive diagnostic tests. According to a report by BIS Research, the global liquid biopsy market size was valued at $2,508.2 Million in 2021 and is expected to grow at a CAGR of 19.83% from 2022-2032. The market is expected to be driven by the increasing demand for early cancer detection, personalized medicine, and the development of new technologies for liquid biopsy. The United States and Europe are currently the largest markets for liquid biopsy, but the Asia Pacific region is expected to see significant growth in the coming years. Key players in the liquid biopsy market include companies like Guardant Health, F. Hoffmann-La Roche Ltd, and Thermo Fisher Scientific, among others. As the technology continues to improve and become more widely adopted, we can expect to see continued growth in the liquid biopsy market.
Get Free Sample Report on Liquid Biopsy Market - Click Here
Conclusion
Liquid biopsy is a promising new technology that has the potential to revolutionize cancer diagnosis and treatment. It's non-invasive, convenient, and can detect cancer at an earlier stage when it's more treatable. While liquid biopsy has its limitations, its advantages make it a valuable tool in the fight against cancer. As the technology continues to improve and become more widely available, we can expect to see it used more frequently in the clinic, helping doctors to better diagnose and treat cancer.